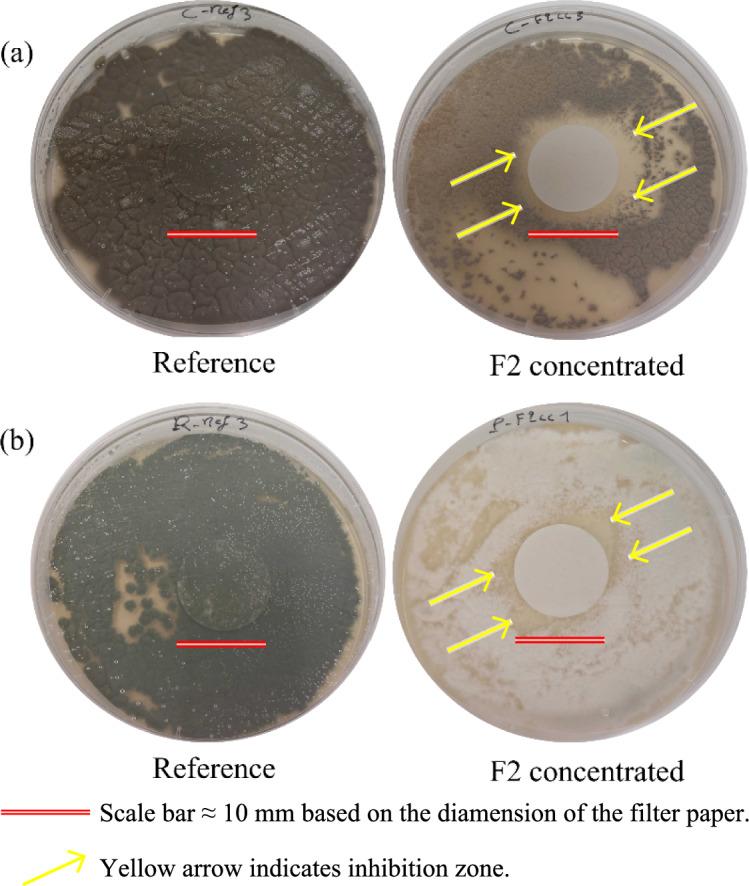
https://cdn.ncbi.nlm.nih.gov/pmc/blobs/f925/12021764/98efa2d5229b/40643_2025_875_Fig8_HTML.jpg

软木树皮碳化液体副产物的性质及抗真菌活性
Properties and anti-fungal activity of liquid by-products from softwood bark carbonization.
作者信息
Zouari Mariem, Poohphajai Faksawat, Meile Kristine, Mikuljan Marica, Herrera Diaz Rene
机构信息
InnoRenew CoE, Livade 6a, 6310, Izola, Slovenia.
Faculty of Mathematics, Natural Sciences, and Information Technologies, University of Primorska, Muzejski Trg 2, 6000, Koper, Slovenia.
出版信息
Bioresour Bioprocess. 2025 Apr 24;12(1):39. doi: 10.1186/s40643-025-00875-8.
This study investigated the potential use of pyrolysis liquid from bark as an anti-fungal substance against food decaying fungi. Four different fractions of pyrolysis liquid were collected during variable temperature phases of the pyrolysis process: F1 (25-260 °C), F2 (260-512 °C), F3 (512-800 °C), and F4 (800-25 °C). The thermal degradation of bark material was assessed using TGA analysis. The concentration, pH, total phenolic content, and functional groups of the liquid samples were determined. Additionally, the molecular composition was examined using UHPLC and QToF mass spectrometry methods. Fungal species were isolated from bell pepper and animal fat and identified through microscopic observation and DNA sequencing. The anti-fungal activity of the liquid fractions was evaluated using the disk diffusion test. The obtained degradation thermograms had a typical shape characteristic of lignocellulosic materials, revealing different thermal degradation phases of the bark. These phases served as a basis for the collection of the pyrolysis liquid in fractions, which were expected to differ in properties and molecular composition. In the fractions collected above 260 ºC (F2, F3, F4), the pyrolysis liquid presented an acidic character, resulting from the complex thermochemical reactions that occur during the slow pyrolysis of bark. F2 had the highest concentration of total phenolic compounds (6.46 mg GAE/g extract) while F1 and F4 contained only negligible amounts. The FTIR spectra of F2 displayed additional peaks compared to other samples which provided information on the occurrence of various compounds. The reversed phase UHPLC-UV analysis revealed that furfural, 5-hydroxymethyl furfural, and 5-methyl furfural were the most abundant compounds, and F2 had the highest concentration of summed furans (570 µg/mL) among all samples. The morphological assessment and DNA sequence analysis of the fungal strains revealed that Penicillium crustosum and Cladosporium sp were isolated from fat and bell pepper, respectively. The antifungal activity of the liquid fractions was limited due to their low concentration (ranging from 0.24% to 0.01% (v/v)), with only minor inhibition observed for F2, indicated by a small inhibition zone of approximately 1 mm around the 10 mm filter paper. However, concentrating the fraction F2 up to 1% (v/v) demonstrated a stronger inhibitory zone against Cladosporium pseudocladosporioides and Penicillium sp., indicating its antifungal potential at higher concentrations. Overall, the pyrolysis liquid demonstrated promising antifungal activity, particularly after concentration, with F2 exhibiting the highest bioactivity and strongest inhibition effect. These findings highlight its potential for controlling food-decaying fungi while emphasizing the need for further purification, toxicity assessments, and application studies to ensure its feasibility for agro-industrial applications.
本研究调查了树皮热解液作为抗食品腐败真菌物质的潜在用途。在热解过程的不同温度阶段收集了四种不同馏分的热解液:F1(25 - 260°C)、F2(260 - 512°C)、F3(512 - 800°C)和F4(800 - 25°C)。使用热重分析(TGA)评估树皮材料的热降解情况。测定了液体样品的浓度、pH值、总酚含量和官能团。此外,使用超高效液相色谱(UHPLC)和四极杆飞行时间质谱(QToF)方法检测了分子组成。从甜椒和动物脂肪中分离出真菌物种,并通过显微镜观察和DNA测序进行鉴定。使用纸片扩散法评估液体馏分的抗真菌活性。所获得的降解热重曲线具有木质纤维素材料典型的形状特征,揭示了树皮不同的热降解阶段。这些阶段为按馏分收集热解液提供了依据,预期不同馏分在性质和分子组成上存在差异。在260℃以上收集的馏分(F2、F3、F4)中,热解液呈酸性,这是树皮缓慢热解过程中发生的复杂热化学反应导致的。F2的总酚化合物浓度最高(6.46 mg GAE/g提取物),而F1和F4仅含有可忽略不计的量。与其他样品相比,F2的傅里叶变换红外光谱(FTIR)显示出额外的峰,这提供了有关各种化合物存在的信息。反相UHPLC - UV分析表明,糠醛、5 - 羟甲基糠醛和5 - 甲基糠醛是最丰富的化合物,并且F2在所有样品中呋喃总量的浓度最高(570 µg/mL)。对真菌菌株的形态学评估和DNA序列分析表明,分别从脂肪和甜椒中分离出了 crustosum青霉和枝孢属真菌。液体馏分的抗真菌活性有限,因为其浓度较低(范围为0.24%至0.01%(v/v)),仅观察到F2有轻微抑制作用,10 mm滤纸周围约1 mm的小抑制圈表明了这一点。然而,将F2馏分浓缩至1%(v/v)对假枝孢镰刀菌和青霉属表现出更强的抑制圈,表明其在较高浓度下具有抗真菌潜力。总体而言,热解液表现出有前景的抗真菌活性,特别是在浓缩后,F2表现出最高的生物活性和最强的抑制效果。这些发现突出了其在控制食品腐败真菌方面的潜力,同时强调需要进一步纯化、毒性评估和应用研究,以确保其在农业工业应用中的可行性。